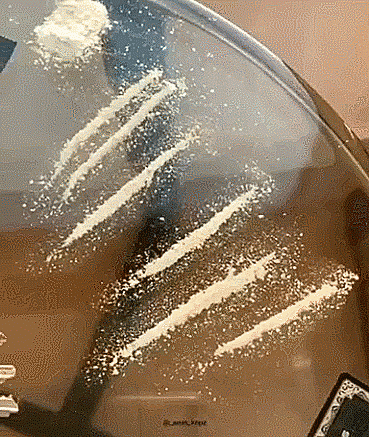
Гифки

3646
15
Включить все анимашки
Подборка гифок на различный вкус.
1.
2.
×
3.
4.
5.
6.
7.
8.
9.
10.
11.
12.
13.
14.
15.
Ссылки по теме:
- 15 эпичных культуристов, которым кажется, что они уже готовы побеждать
- 15 стойких человек которые точно знают, что родовое имя превыше позора
- Киски, вам задача - выбрать круче мачо
- Мастера невозмутимости в естественной среде обитания
- Мопеды: пост о тех, кто ещё не самоубился
реклама